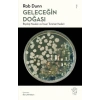
Geleceğin Doğası: Biyoloji Yasaları ve İnsan Türünün Kaderi
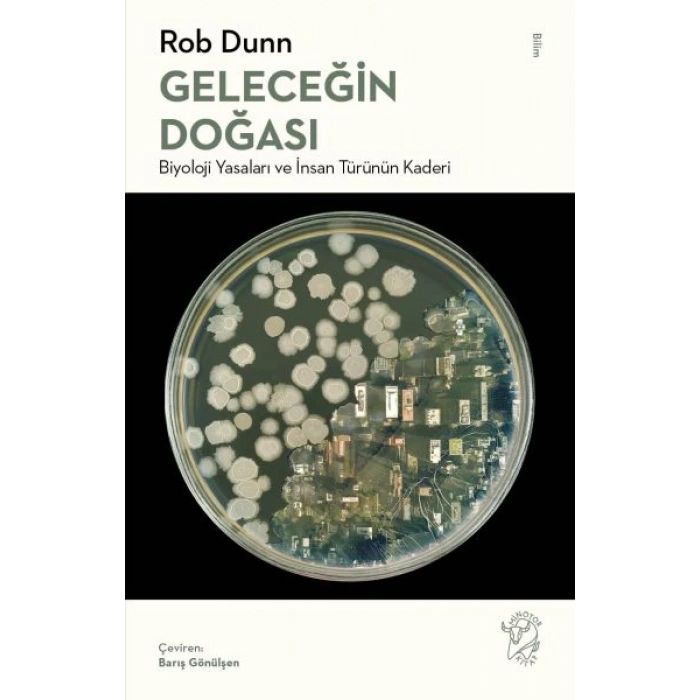
Geleceğin Doğası: Biyoloji Yasaları ve İnsan Türünün Kaderi

Kategoriler
 EV & YAŞAM
EV & YAŞAM
 ELEKTRONİK
ELEKTRONİK
 YAPI MARKET
YAPI MARKET
 SÜPERMARKET
SÜPERMARKET
 HIRDAVAT
Elektrikli El Aletleri El Aletleri Menfez Çeşitleri Sıhhi Tesisat Ürünleri Askılık Güvenlik Ekipmanları Mutfak Ürünleri Ev Gereçleri Bahçe Ürünleri Temizlik Yağ & Sprey & Bakım Yapıştırıcı ve Silikonlar Kutu & Çantalar Tamir Ürünleri Dubel & Vida & Çivi Çeşitleri Elektronik Lazer Terazi Diğer Hırdavat Malzemeleri Elektrik Tesisat Ürünleri Koruyucu Ekipmanlar
HIRDAVAT
Elektrikli El Aletleri El Aletleri Menfez Çeşitleri Sıhhi Tesisat Ürünleri Askılık Güvenlik Ekipmanları Mutfak Ürünleri Ev Gereçleri Bahçe Ürünleri Temizlik Yağ & Sprey & Bakım Yapıştırıcı ve Silikonlar Kutu & Çantalar Tamir Ürünleri Dubel & Vida & Çivi Çeşitleri Elektronik Lazer Terazi Diğer Hırdavat Malzemeleri Elektrik Tesisat Ürünleri Koruyucu Ekipmanlar KAMPÇILIK
KAMPÇILIK
 KIYAFET
KIYAFET
 İNDİRİMLİ ÜRÜNLER
İNDİRİMLİ ÜRÜNLER
- Tümünü Gör